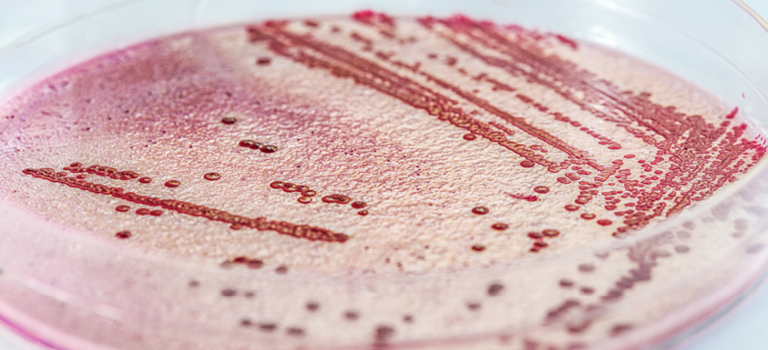
24-timers listeriaanalyse

- En bakterie som finnes naturlig i jord, vann og miljøet rundt oss
- Kan overføres til mat via produksjonsmiljø og utstyr
- Danner biofilm og kan være vanskelig å fjerne
Listeria monocytogenes
Nye krav til spiseklar mat – er du forberedt?
Nå skjerpes EU-regelverket for Listeria monocytogenes i spiseklar mat. Det vil ikke lenger være nok å teste ved produksjon – fravær av Listeria må kunne dokumenteres gjennom hele produktets holdbarhet, med mindre det kan vises at nivået ikke overstiger 100 CFU/g. Endringen i Mikrobiologiske kriterier for næringsmidler (Kommisjonsforordning (EF) nr. 2073/2005) kommer som følge av økt forekomst av listeriose i EU og skal styrke forbrukerbeskyttelsen – særlig for sårbare grupper.
Hva er nytt?
Cecilie From, mattrygghetsekspert og leder for de mikrobiologiske avdelingene til Eurofins i Sør-Norge, forteller deg hvordan endringene som inntrer i 2026 vil påvirke deg som produsent av spiseklar mat:
Fakta om Listeria
- En av de største utfordringene for produsenter av spiseklar mat
- Kan gi alvorlig sykdom, særlig hos gravide, eldre og personer med svekket immunforsvar
- Påvisning kan føre til produksjonsstans, økte kostnader og tilbaketrekking av produkter
Mikrobiologiske kriterier for næringsmidler (Kommisjonsforordning (EF) nr. 2073/2005) angir grenseverdier for L. monocytogenes i spiseklar mat der bakterien kan vokse.
Hva kan vi bistå med?
Med vår ekspertise kan vi hjelpe deg i møte med de nye listeria-kravene. Vi tilbyr blant annet:
- Tolkning av regelverket – vi hjelper deg å forstå hva endringen betyr for din virksomhet
- Risikovurderinger – identifisering av kritiske punkter i produksjonskjeden
- Matematisk modellering – prediksjon av Listeria-vekst gjennom holdbarhet
- Akkrediterte belastningsstudier – i tråd med EU-krav
- Dokumentasjon og rådgivning – for å sikre samsvar og trygghet før regelverket trer i kraft
Endringene innebærer at du som matprodusent må:
- Oppdatere HACCP-planer og rutiner for mikrobiologisk testing
- Gjøre en vurdering av om Listeria monocytogenes kan vokse i produktet ditt, og eventuelt dokumentere at bakterien ikke vokser til over 100 CFU/g i løpet av holdbarheten
- Dersom du ikke vet hvordan Listeria monocytogenes vokser i produktet, må krav om fravær av bakterien i 25 g overholdes i hele holdbarhetstiden
- Vurdere endringer i produksjon, emballering og lagring
Kontakt
Ønsker du å vite mer om betydningen av regelverksendringen for din bedrift, ta kontakt med vår fagekspert:
Åse Lyngved Holstad
Analytical Service Manager, Microbiology
mat@ftn.eurofins.com
Forebygging, tiltak og påvisning
Det er avgjørende å bekjempe Listeria gjennom strenge kontrollrutiner og testing for å sikre trygg mat. Eurofins Food & Feed Testing Norway AS tilbyr en rekke tjenester relatert til listeria-kontroll.